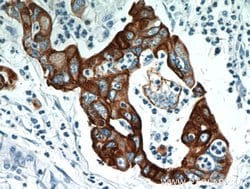
Cytokeratin 18 Rabbit anti-Human, Mouse, Polyclonal, Proteintech:Antibodies:Primary
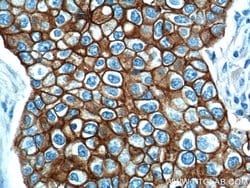
Cytokeratin 18 Rabbit anti-Human, Mouse, Polyclonal, Proteintech:Antibodies:Primary

Promotional price valid on web orders only. Your contract pricing may differ. Interested in signing up for a dedicated account number?
Learn More
Learn More
Cytokeratin 18 Rabbit anti-Human, Mouse, Polyclonal, Proteintech


Rabbit Polyclonal Antibody
$518.60
Specifications
| Antigen | Cytokeratin 18 |
|---|---|
| Concentration | 0.19 mg/mL |
| Applications | Flow Cytometry, Immunocytochemistry, Immunofluorescence, Immunohistochemistry (Paraffin), Immunoprecipitation |
| Classification | Polyclonal |
| Conjugate | Unconjugated |
| Catalog Number | Mfr. No. | Quantity | Price | Quantity & Availability | |||||
|---|---|---|---|---|---|---|---|---|---|
| Catalog Number | Mfr. No. | Quantity | Price | Quantity & Availability | |||||
50-553-325
 
|
Proteintech Group Inc
108301AP150UL |
150 μL |
Each of 1 for $518.60
|
|
|||||
Description
Cytokeratin 18 (Keratin 18, KRT18, type I cytoskeletal 18) belongs to the type A (acidic) subfamily of low molecular weight keratins, exists in combination with cytokeratin 8. Tissues from gastrointestinal tract, respiratory tract and urogenital tract, as well as endocrine and exocrine tissues and mesothelial cells are positive for cytokeratin 18. Further, cytokeratin 18 is found primarily in non-squamous epithelia and is present in a majority of adenocarcinomas and ductal carcinomas, but not in squamous cell carcinomas. Hepatocellular carcinomas express only cytokeratins 8 and 18. Mutations in the cytokeratin 18 gene have been linked to cryptogenic cirrhosis. Two transcript variants encoding the same protein have been found for the cytokeratin 18 gene. Cytokeratin subtype expression patterns are used to an increasing extent in the distinction of different types of epithelial maligcies. The cytokeratin antibodies are not only of assistance in the differential diagnosis of tumors using immunohistochemistry on tissue sections, but are also a useful tool in cytopathology and flow cytometric assays.Specifications
| Cytokeratin 18 | |
| Flow Cytometry, Immunocytochemistry, Immunofluorescence, Immunohistochemistry (Paraffin), Immunoprecipitation | |
| Unconjugated | |
| Rabbit | |
| Human, Mouse | |
| P05783, P05784 | |
| 16668, 3875 | |
| Cytokeratin 18 Fusion Protein Ag1260 | |
| Primary | |
| -20°C | |
| KRT18 |
| 0.19 mg/mL | |
| Polyclonal | |
| Liquid | |
| RUO | |
| PBS with 50% glycerol and 0.1% sodium azide; pH 7.3 | |
| CK 18, CYK18, Cytokeratin 18, K18, keratin 18, KRT18 | |
| KRT18 | |
| IgG | |
| Antigen Affinity Chromatography | |
| Antibody |
Spot an opportunity for improvement?Share a Content Correction
Product Content Correction
The Fisher Scientific Encompass Program offers items which are not part of our distribution portfolio. These products typically do not have pictures or detailed descriptions. However, we are committed to improving your shopping experience. Please use the form below to provide feedback related to the content on this product.
Product Title